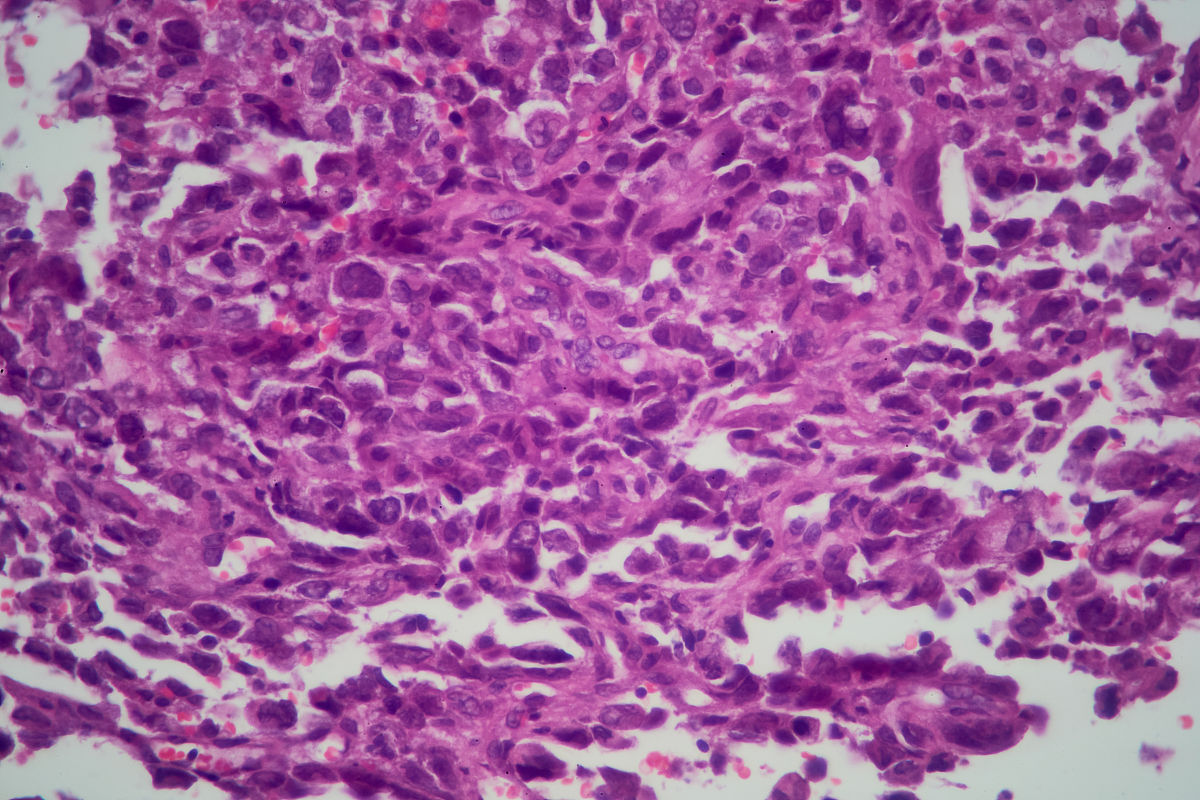
曾经被诊断为低分化腺癌并接受过治疗。低分化腺癌复查结论为：肺组织中见低分化癌浸润部分细胞伴退变。怎么解读这个结论属于复发吗？部分癌细胞发生了退变属于什么情况？是好还是不好？

曾经被诊断为低分化腺癌并接受过治疗。低分化腺癌复查结论为:肺组织中见低分化癌浸润部分细胞伴退变。怎么解读这个结论属于复发吗?部分癌细胞发生了退变属于什么情况?是好还是不好?
根据提供的信息,复查结果显示肺组织中存在低分化腺癌浸润,并且部分癌细胞发生了退变。这个结论可以解读为低分化腺癌在肺组织中有复发或进展的迹象。
部分癌细胞发生退变可能指的是这些癌细胞发生了一些形态或结构上的改变,可能与治疗或其他因素有关。这种情况下,可能有一部分癌细胞变得不像原始的低分化腺癌细胞,而是呈现出更不成熟或更异常的特征。
由于我们无法提供更多的详细信息,无法确定这种情况对患者是好还是不好。建议您咨询您的医生,以便获得更准确的解读和进一步的治疗建议。
原文地址: https://www.cveoy.top/t/topic/iQCC 著作权归作者所有。请勿转载和采集!